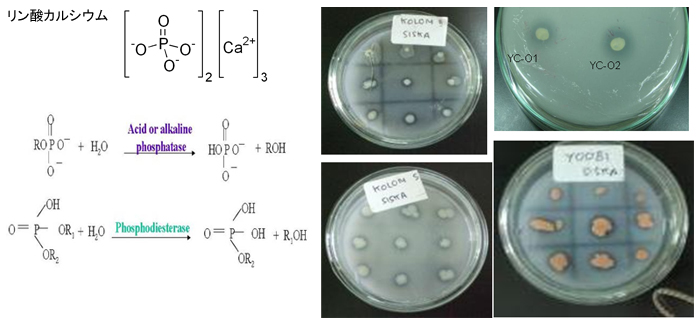

石油分解遺伝子の多様性
石油分解遺伝子の解析
インドネシア海水から分離した石油分解菌について、それぞれの株が持つと予想される石油分解酵素遺伝子をPCRによって確認しました。 アルカン分解の初発反応は、末端メチル基の水酸化であり、その反応を触媒する酵素の一つにAlkane monooxygenase (AlkB)があります。一方、芳香族炭化水素分解の初発反応は、Ring-hydroxylating dioxygenaseによる二つの水酸基の芳香環への導入です。これらをターゲットにしたPCRを行い、増幅されたDNA断片の配列を決定しました。
アルカンモノオキシゲナーゼ遺伝子の多様性
アルカン分解細菌のうち、選別した40株について、アルカン分解の初発の酸化反応を担うAlkane monooxygenase 遺伝子(AlkB)をPCRによって増幅しました。34株で増幅が確認されました。クローニングを行いAlkBの配列を決定しました。その推定アミノ酸は、配列の相同性検索をblastxによって行ったところ、既知のAlkB配列に対し、約80~95%の相同性を示しました。 系統解析の結果、これまでに知られている3種類のAlkBタイプすべてが確認され、インドネシア株は多様なアルカンモノオキシゲナーゼを有することが確認されました。系統学的に新規性の高い株からは、新規性の高いAlkBが確認されました。アルカンに対して分解能力が高いことが知られているAlcanivorax属、Marinobacter属では、2種類以上のAlkBが確認されました。また、既知菌株に対して16S rRNA遺伝子の相同性が高くても、AlkB遺伝子は異なることが確認されました。その一方で、AlkBホモログ遺伝子がAlcanivorax属、Marinobacter属、Stappia属、Thalassospira属の異なる属で確認され、ある共通のAlkBが海水中に普遍的に存在する可能性が示唆されました(【図1】)。

ジオキシゲナーゼ遺伝子の多様性
PAH分解細菌のうち、選別した300株について、芳香環への初発の酸化反応を担う二酸素原子添加酵素(ジオキシゲナーゼ)遺伝子をPCRによって増幅しました。184株で増幅が確認され、このうち70株についてクローニングを行いました。その推定アミノ酸配列の相同性検索をblastxによって行ったところ、既知のジオキシゲナーゼ配列に対し、約40~95%の相同性を示しました。 系統解析の結果、これまでに知られている4種類すべてが確認され、インドネシアPAH分解菌株の保持するジオキシゲナーゼは、アルカン分解細菌の場合と同様に多様性に富んでいました。しかし、実験に供した菌株のうち約半数については、既報の6種類のプライマーを用いたPCRにおいても増幅が見られませんでした。このことからインドネシア株には、既報のものとは異なる新規性の高いジオキシゲナーゼが存在することが示唆されました。特に、Alphaproteobacteriaの系統学的に新規性の高い株においては、そのジオキシゲナーゼの新規性が高いことがわかりました。(【図2】)。

以上をまとめると、以下のようになります(【図3】)。

インドネシアで分離した石油分解菌について、炭化水素分解の初発反応を触媒する酸素添加酵素遺伝子の塩基配列を解析しその結果、多様かつ新規性の高い炭化水素分解酵素(モノオキシゲナーゼ・ジオキシゲナーゼ)遺伝子が存在していました。また、16S rRNA遺伝子の相同性が高くても、相同性の低い炭化水素分解酵素遺伝子を持つ場合がありました。
熱帯海域の石油汚染現場での石油分解菌
熱帯海域で実際に起きた原油流出事故において、どのような石油分解菌が出現するかを明らかにするため、インドネシア海域の石油汚染現場のサンプルについて以下のとおり調査しました。
漂着油
熱帯海域で実際に起きた原油流出事故において、どのような石油分解菌が出現するかを明らかにするため、インドネシア海域の石油汚染現場のサンプルについて以下のとおり調査しました。
インドネシア沿岸海域から採取した漂着油の成分を解析したところ、炭素鎖の短いアルカンについては、分解がかなり進んでいました(【図4】)。

この漂着油からDNAを抽出し、そのDNAからrRNA遺伝子の部分配列を増幅しました。このDNA断片をクローン化後、塩基配列を決定することにより、漂着油に付着している細菌の分類学的位置について解析しました。 クローンの上位には、MarinobacterやOceanobacterが位置しました。これらのクローンに対応する細菌の7割については、分離・培養に成功しています(【図5】)。

漂着油は、多様かつ新規な石油分解菌を含んでいました。これは、十分な栄養塩を含む原油培地では、石油分解菌の多様性が非常に低くなることと対照的でありました(【図6】)。

流出重油
インドネシア、スラバヤのTanjung Perak港で起きた重油流出事故の流出油を採取し、その細菌群集構造を解析しました(【図7】)。

16S rRNA遺伝子クローンライブラリー解析の結果、流出石油ではGammma-proteobacteriaが76 %を占めていることが分かりました。属レベルでは、Oceanobacter属が49%、Alcanivorax属が13%、Marinobacter属が6%の割合で優占化していました。Alcanivorax属及びMarinobacter属は、原油と栄養塩を含む海水のバッチ培養においても検出されています。Oceanobacter属は、バッチ培養では検出されませんでしたが、インドネシア各地の海水から石油分解菌を直接分離した際に多く分離されており、非汚染の海水中における存在比が高いことが示唆されています。さらに、流出重油から単離したDNAを用いたDGGE解析の結果からも、Oceanobacter属が高度に優占化していることが確かめられました。一方、周辺海水中のDGGEプロファイルにおいてはOceanobacter属のバンドの存在比は小さく、Oceanobacter属が流出重油中で活発に増殖する、又は、流出重油に付着しやすい性質をもつことが推定されました。Oceanobacter属が石油汚染に対応して優占化するという報告は本調査が初めてであり、興味深い知見であると考えられます。(【図8】)。

以上、様々な状況で出現するアルカン分解細菌は、大きく分けてAlcanivorax、Marinobacter、Oceanobacterの三つの属が確認されました。
Alcanivoraxは、栄養塩及び酸素が十分に供給されたとき優占化します。Marinobacterは、栄養塩濃度が不十分なときに優占化します。この細菌は、硝酸呼吸を行うので嫌気的条件下でも増殖します。また、リン酸カルシウムのリン成分を利用できます。Oceanobacterは、原油汚染された海水中、貧栄養条件下で優占化します。 なぜ特定の石油分解菌が特定の条件で優占化するのかの理解は、緒についたばかりです。このメカニズムを完全に理解することで、状況に併せて、特定の石油分解菌を環境浄化に利用するような技術も開発できるでしょう。
なお、【図9】に、Marinobacter等がリン酸カルシウムを利用できることを示します。

以上、インドネシア海域の石油汚染現場のサンプルの解析から、以下のことが明らかになりました。
- 現場海岸漂着油には多様な石油分解菌が存在していました。
- 熱帯海域環境中での石油汚染物質の自然分解(ナチュラルアテニュエーション)には、多様な細菌が関与していると考えられました。
- 原油流出事故での流出重油中でAlcanivorax属、Marinobacter属及びOceanobacter属が高い比率で存在し、これらの細菌がインドネシア海域での石油分解に重要であると考えられます。
インドネシア海域で1,500株以上の細菌を単離し、そのうちの691株を日本に移転しました。これらには、新属・新種候補186株が含まれています(【図11】)。

これらの菌株については準備が整いしだい、菌株の提供ページから提供される予定です。
- 実施概要
- 石油分解菌の検出とその多様性
- 石油分解遺伝子の多様性
- 石油分解菌の特性の解明
- 石油分解菌を活性化する条件の検討
- 収集した菌株の提供
お問い合わせ
- 独立行政法人製品評価技術基盤機構 バイオテクノロジーセンター バイオ技術評価・開発課(かずさ)
-
TEL:0438-20-5764
住所:〒292-0818 千葉県木更津市かずさ鎌足2-5-8 地図
お問い合わせフォームへ








